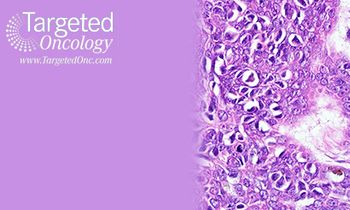

Articles by Kamana Misra, PhD

Diagnosis of acute myeloid leukemia (AML) is pivoted around cytogenetic analysis of patient bone marrow or peripheral blood cultures. The World Health Organization classification of tumors of the hematopoietic and lymphoid tissues is based on cytogenetic features along with other clinical, morphological, and immunophenotypic characteristics.

Bladder cancer remains the costliest cancer to treat per capita, taking into account diagnostic testing, management, and long-term follow-up. Continued development of urine-based biomarker diagnostic tests may help replace the costly and more invasive techniques of imaging, cytology, and cystoscopy for cancer detection. Genome-wide expression and sequencing studies have identified genes and pathways considered key drivers of bladder cancer.

In a new study, researchers investigated the roles of Dicer in replication-associated DNA damage during development. The team chose a model of the developing cerebellum for the study.

A team from the Scripps Research Institute and Bristol-Myers Squibb recently collaborated to collectively develop a method for complete chemical synthesis of antroquinonol and to test the biologic activity of the chemically synthesized product. Contrary to previous reports, the study reported minimal in vitro and in vivo antitumor activity of chemically synthesized antroquinonol A.

Although FGFR pathway deregulation has been identified frequently in NSCLC, clinical activity of FGFR inhibitors has been considered disappointing and modest, at best, to date.
Although single-target inhibitors and have demonstrated significant clinical benefit, the toxicities are not limited to cancer cells alone and associated toxicities and adverse events are often observed.

Androgen deprivation therapy has been the standard of care for patients with advanced prostate cancer (PC), because these agents inhibit cancer progression in the early stages of disease.

Oncoviruses have been implicated to cause 17.8% of human cancers.

A recent study published by David Pepin, PhD, et al shows a promising gene therapy treatment that can inhibit tumor growth in preclinical models of serous ovarian cancer.

Early detection of metastasis in patients with breast cancer, which is critical for designing effective targeted therapies, has unfortunate limitations with prevalent screening methods. A study published in Nature Communications has shown promise for extending the detection limit of the current clinical imaging technology

Rosemary Cress, MPH, PhD, and colleagues sought to identify long-term survival of patients with epithelial ovarian cancer, as well as the epidemiological characteristics associated with such survival.

There has been a preponderance in the healthcare industry to overtreat early-stage, slow-progressing prostate cancer, often subjecting patients to unwarranted, life-altering treatments.

In addition to late patient presentation, the high mortality rate in lung cancer can be largely attributed to the complex nature of the disease and a very high rate of heterogeneity in the causative molecular abnormalities.

Current trends and recent advances have reinforced the superiority of combined inhibition of BRAF/MEK in melanoma treatment, according to Michael A. Davies, MD, during a summary of studies in melanoma.

Abnormal driver mutations contribute to tumor progression and have been prime targets for many therapeutic studies in oncology; however, researchers are focusing more and more on the less-studied passenger mutations and their role in tumor progression.

Cancer proliferates when a rogue, transformed cell wins a sophisticated hide-and-seek game against the immune system. Immunotherapy activates the patient’s immune system to recognize and fight the tumor cells.

Early detection in lung cancer is strongly linked to better survival. In a landmark decision the CMS recently approved national coverage for lung cancer screening with LDCT for high-risk smokers.